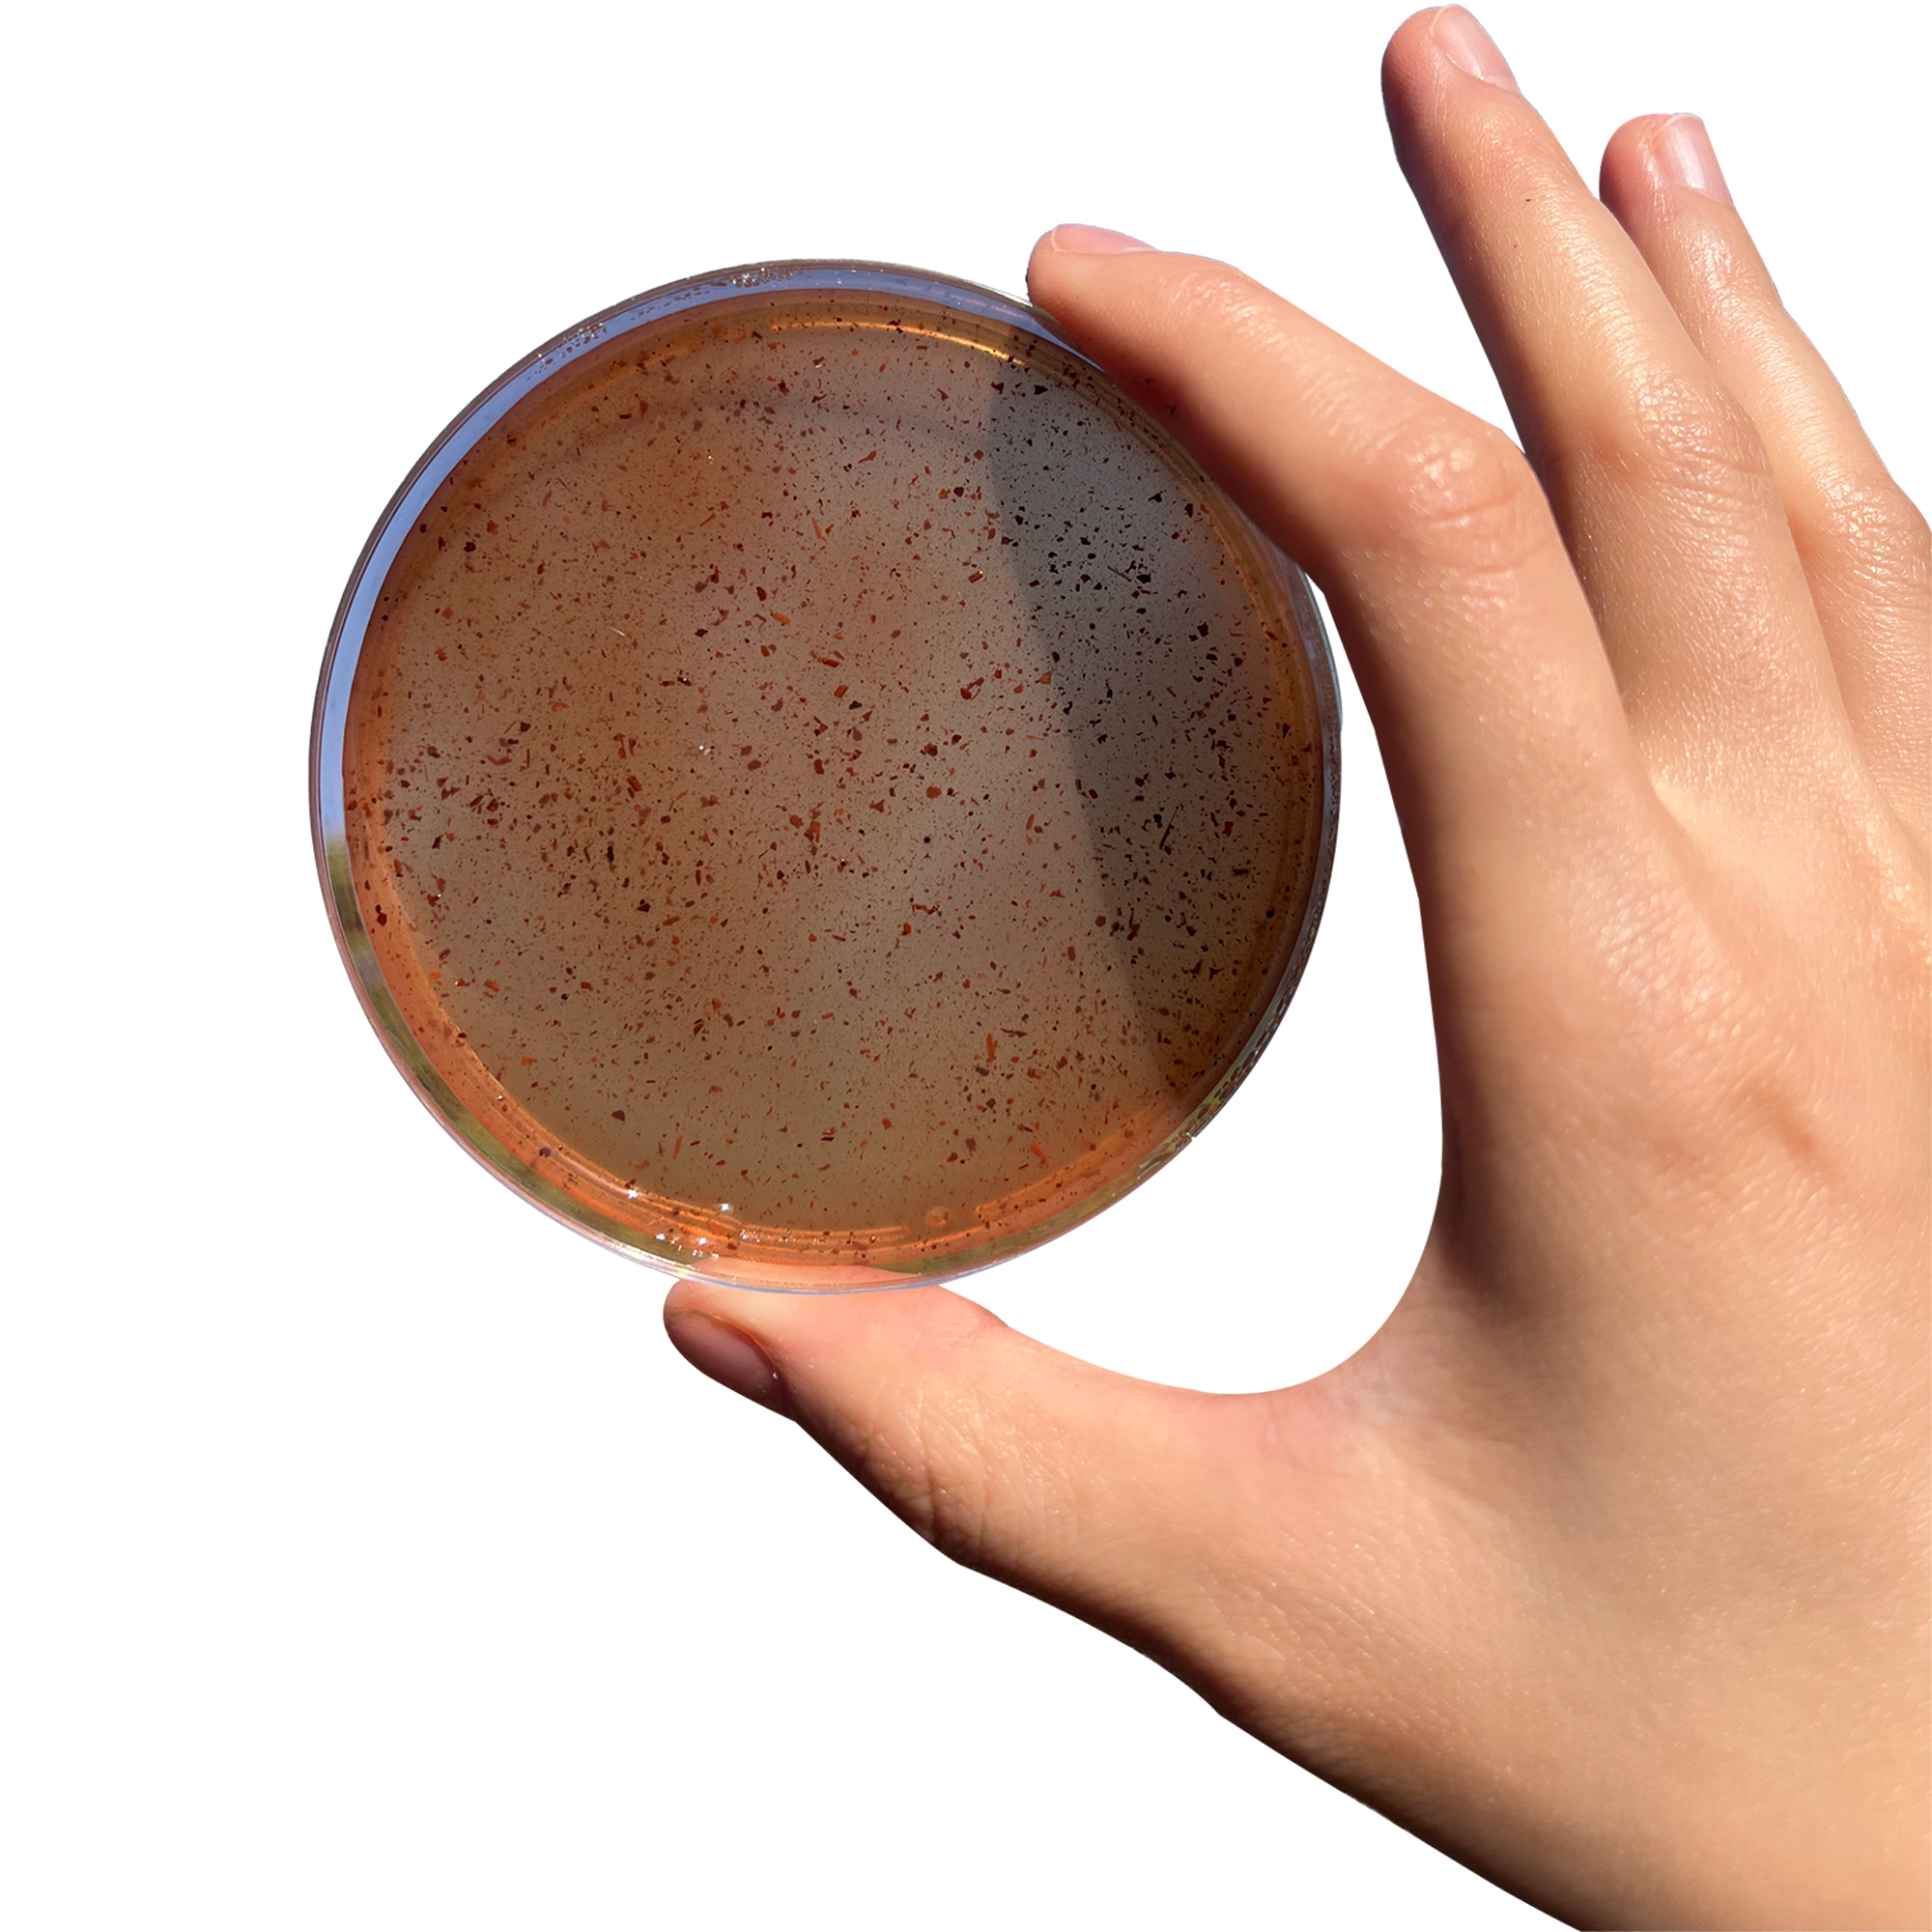

Ziyao Peng
I'm a visual and sustainable designer who is currently studying at the Design School Kolding in Denmark. I concentrate on creating eco-friendly materials and enjoy exploring diverse mediums in my designs.
Q&A
Artist Statement
The work involves experimenting with local agricultural by-products, olive leaves, and avocado leaves to explore how controlling the proportions and methods of production can yield bio-materials with different properties. Research was conducted in natural settings to understand that there are many overlooked materials locally. The process involved exploring whether these can be repurposed and transformed into new products. |
Media & Contact
Representation
Freelancing
Contact
Email: 2022K044@dskd.dk
References
Website: https://yolab.cc/project/greek-fieldlab
Instagram: koniu188
Photography credit
Ziyao Peng, Crete, Greek
Location
Denmark